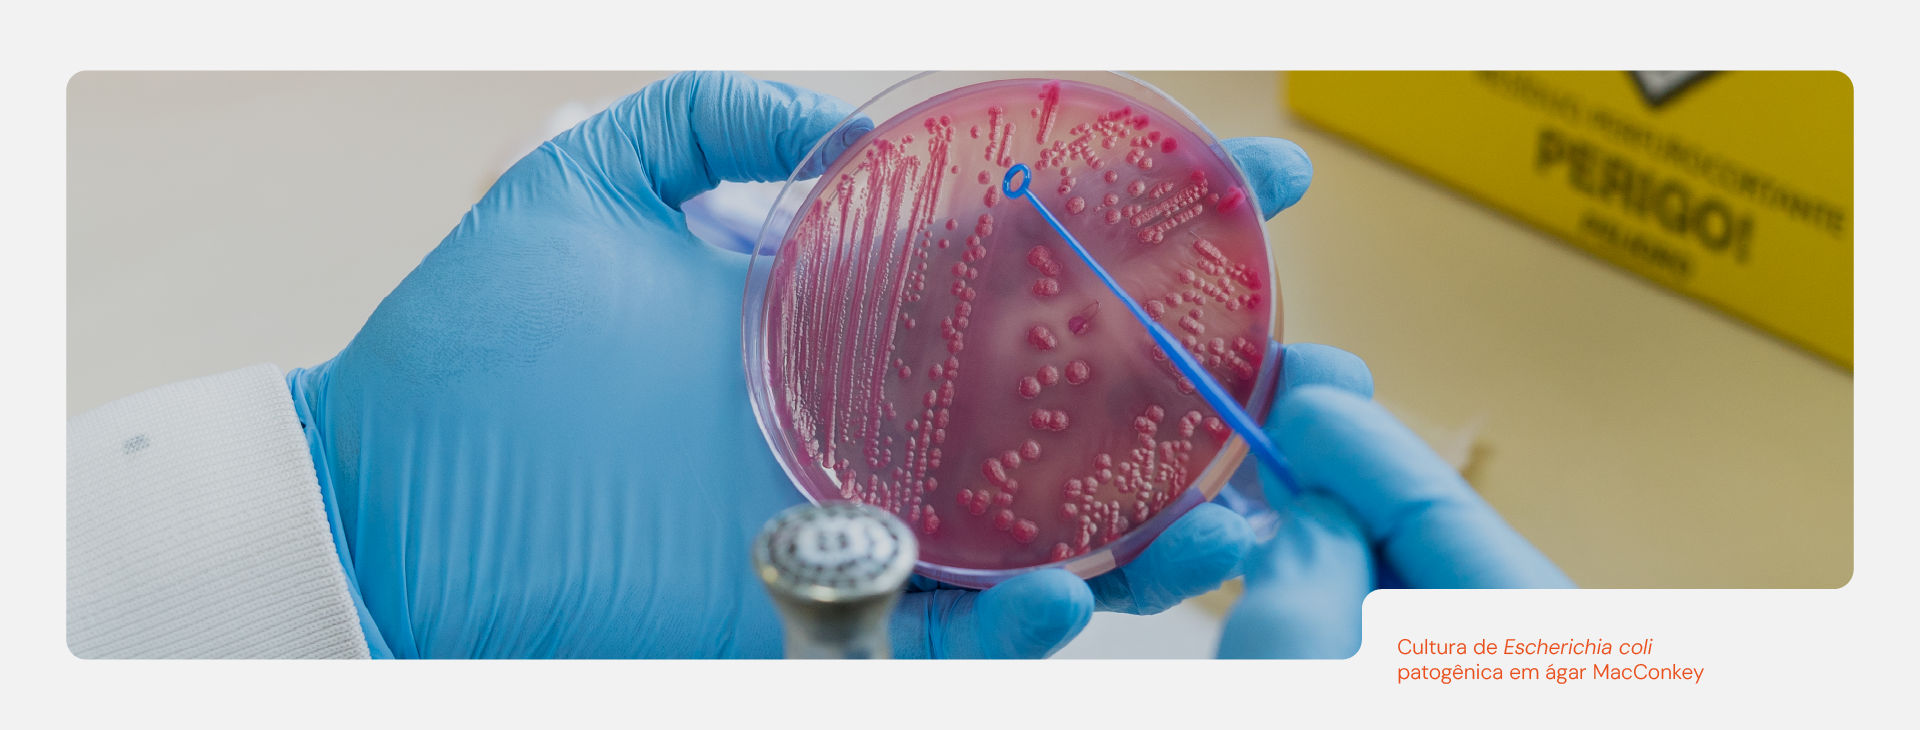
imagem
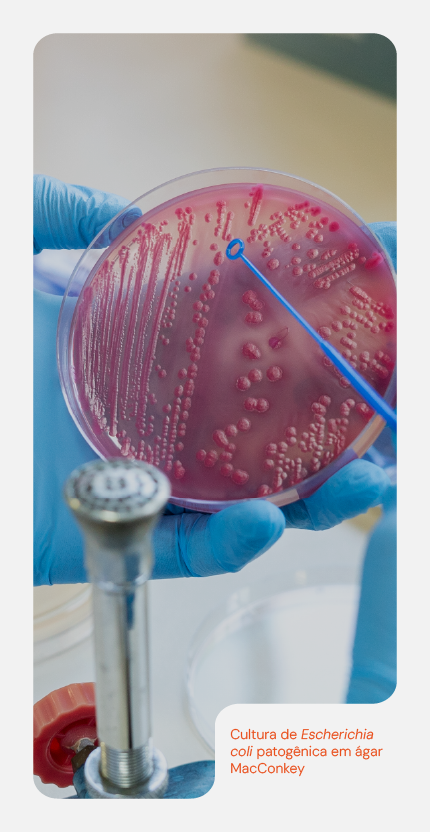
imagem

O que é o CDC?
O Centro de Desenvolvimento Científico (CDC) do Instituto Butantan é responsável por desenvolver pesquisa básica e direcionada, com forte interface com a pesquisa aplicada e translacional.
Sua atuação se apoia em três pilares estratégicos:
- Produção de conhecimento científico de excelência
- Formação de recursos humanos altamente qualificados
- Inovação e resposta em saúde pública
BAC
CDA
LBE
LBQ
LCC
LCZ
LDV
LED
LF
LFP
HERP
LIG
LIP
PAR
LETA
LEEV
NBBC
Educação e formação
O CDC abriga a Pró-Reitoria de Pesquisa e Pós-Graduação (proPPG) do Instituto Butantan desde 2010, oferecendo
Iniciação Científica (PIBIC/PIBITI - CNPq)
Pós-Graduação Stricto Sensu (CAPES)
- Mestrado/Doutorado em Toxinologia
- Mestrado Profissional em Biotecnologia e Bioprocessos
Programa de Pós-Doutorado Institucional
Rotas tecnológicas
O CDC organiza sua pesquisa em duas rotas tecnológicas:
Rota I - Dos animais peçonhentos à terapêutica
Biologia, evolução e conservação dos animais peçonhentos
Caracterização de venenos e toxinas
Aplicações em saúde pública:
- Melhoria de antiveneno
- Descoberta de novos fármacos
- Desenvolvimento de mecanismo terapêuticos
Rota II - Do patógeno ao combate: vacinas, diagnóstico e terapias
Biologia e diversidade de patógenos e vetores
Caracterização de moléculas e mecanismo de patogenicidade
Estudos de modulação do sistema imune
Aplicações em saúde pública:
- Vigilância e controle
- Desenvolvimento de vacinas e diagnósticos
- Descoberta de novos fármacos
Notícias